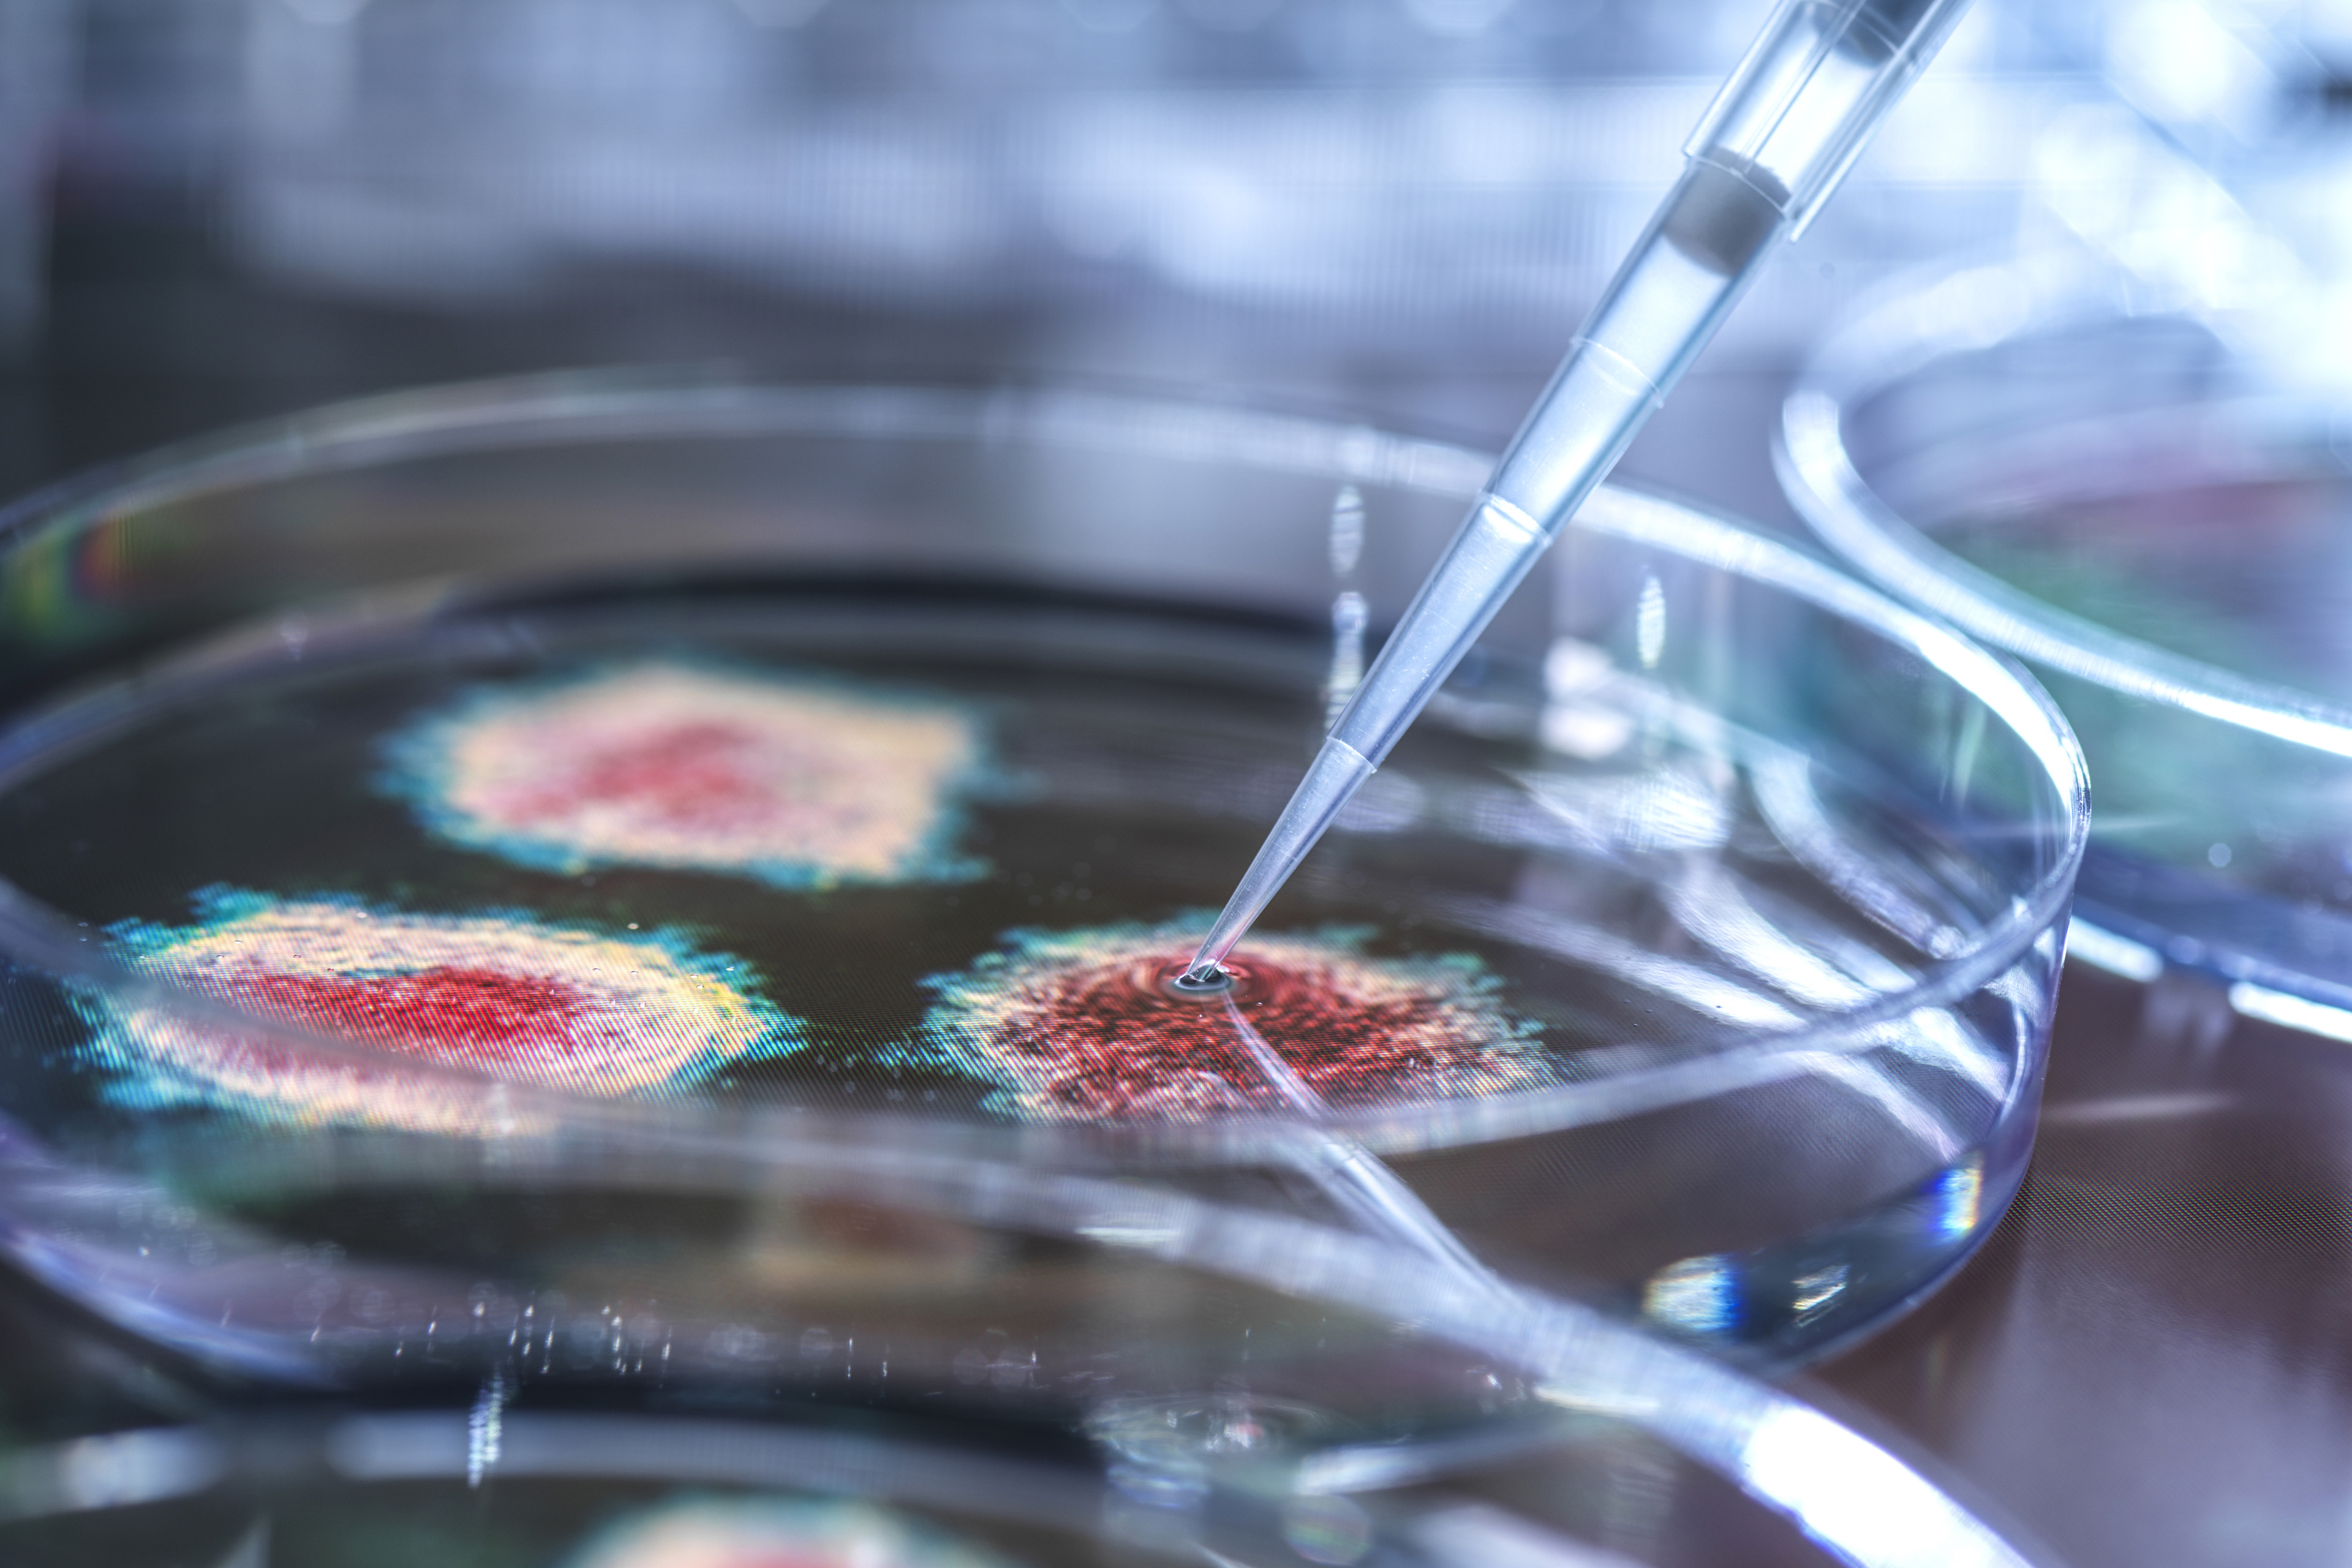

Die internationale EY-Organisation besteht aus den Mitgliedsunternehmen von Ernst & Young Global Limited (EYG). Jedes EYG-Mitgliedsunternehmen ist rechtlich selbstständig und unabhängig und haftet nicht für das Handeln und Unterlassen der jeweils anderen Mitgliedsunternehmen. Ernst & Young Global Limited ist eine Gesellschaft mit beschränkter Haftung nach englischem Recht und erbringt keine Leistungen für Mandanten.
Life Sciences
Unsere Beratung im Life-Sciences-Sektor hilft Ihnen, neue Wege zu gehen – in einem Ökosystem, in dem die Gesundheit der Menschen im Mittelpunkt steht.
Perspektiven
Die deutsche Biotech-Branche und der globale Wettlauf
Erfahren Sie im German Biotechnology Report 2025, wie sich die deutsche Biotech-Branche im internationalen Wettlauf positioniert.
Wie Unternehmen aktuellen Trends im Gesundheitsbereich begegnen können
Erfahren Sie hier, wie neue Technologien, ESG-Vorgaben und personalisierte Medizin die Pharmaindustrie verändern.
Entdecken Sie die transformative Kraft der KI in der Biotech-Branche. Erfahren Sie, wie Innovationen und Herausforderungen die Zukunft gestalten.
Warum das Gesundheitssystem unter der Klimakrise leidet
Die Gesundheitsbranche steht vor großen Herausforderungen: Klimakrise oder die eigene Rolle als Emissionen-Verursacher. Was nun zu tun ist, lesen Sie hier.
Cyberangriffe: Wie sich Medizinprodukte-Hersteller schützen können
Lesen Sie hier, wie Unternehmen aus der Medizintechnik vor Hackern geschützt werden können und warum es sich lohnt, in Cybersicherheit zu investieren.
Wo Biotechnologie steht – und welches Standing sie haben sollte
Wo steht Biotechnologie und welches Standing sollte sie haben? Analysen und Schlussfolgerungen lesen Sie im Biotechnologie-Report 2023 von EY.
Wie Digitalisierung Wertschöpfungsketten verändert
Chemieunternehmen können die Kreislaufwirtschaft nutzen, um langfristige Werte zu schaffen. Wie das möglich ist, erläutert Matthias Brey von EY hier.
Warum der IPO-Markt für Biotechs jetzt boomt
Die Beteiligung Crossover-Investoren vor dem Börsengang zählt zur Best Practice im Bereich Biotech und ist fester Bestandteil des IPO Readiness Prozesses.
Startups, die durch den Magen gehen – Teil 2: Next Generation Nutrition
Im ersten Teil unserer Artikel-Reihe haben wir einen Überblick über das deutsche FoodTech-Ökosystem gegeben und die sieben größten Industrietrends vorgestellt (Startups, die durch den Magen gehen – Teil 1: Das deutsche FoodTech-Ökosystem). Teil 2 geht einen Schritt weiter und startet mit einem Deep Dive in das Trend-Segment Next Generation Nutrition.
Wie KI schon heute die Medizin der Zukunft prägt
Algorithmen und Software-Intelligenz haben einen großen Einfluss auf unser Leben. Fünf konkrete Beispiele aus dem Bereich Healthcare.
So unterstützen wir Sie
-
Lesen Sie hier, wie Unternehmen im Bereich Biowissenschaften mit personalisierten Kundenerlebnissen ihre Wettbewerbsposition stärken können.
Mehr erfahren -
Unsere Methodik ermöglicht es Ihnen, zu ergebnisbasierten Vergütungsmodellen zu wechseln und dabei den ergebnisbasierten Vertrag auch taktisch zu nutzen.
Mehr erfahren
Direkt in Ihr E-Mail Postfach
Bleiben Sie auf dem Laufenden mit unserem Newsletter